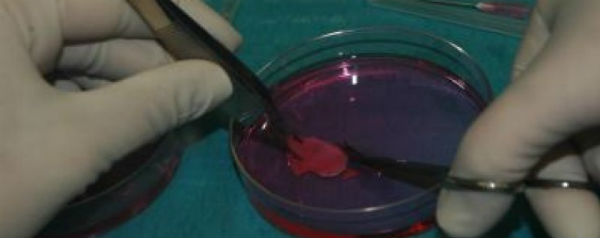

Voor het eerst is er een koter ter wereld gekomen met getransplanteerd eierstokweefsel afkomstig van een kind.
Dat er een baby wordt geboren met teruggeplaatst eierstokweefsel is niet nieuw. In totaal kwamen er al zo’n veertig kinderen ter wereld dankzij de techniek. Maar België heeft nu een primeur: een vrouw is hier bevallen van een gezonde baby, nadat eierstokweefsel dat op haar dertiende bij haar was afgenomen weer werd ingebracht. Dit is de eerste keer dat getransplanteerd eierstokweefsel van een kind uiteindelijk leidt tot een geboorte.
Chemotherapie
De Congolese vrouw, die overigens anoniem wil blijven, kreeg op haar vijfde de diagnose sikkelcelanemie. Toen ze 13 jaar oud was, emigreerde ze naar België, waar artsen besloten haar ziekte te behandelen met een beenmergtransplantatie. Voorafgaand aan deze operatie moest ze chemotherapie ondergaan, zodat haar immuunsysteem het beenmerg niet zou afstoten.
De artsen waren zich ervan bewust dat de chemotherapie de werking van haar eierstokken kon stopzetten. Daarom verwijderden ze haar rechter eierstok en bevroren stukjes weefsel ervan. Dit werd beschouwd als onvolwassen eierstokweefsel, aangezien het meisje nog niet ongesteld was geworden. Haar linker eierstok stopte met functioneren toen ze 15 jaar werd.
Kerngezonde zoon
Tien jaar later liet de vrouw weten dat ze toch graag een kindje wilde. De doktoren zetten vier stukken van het bevroren weefsel terug in de overgebleven eierstok en elf in de rest van haar lichaam. De vrouw begon vervolgens zelf eitjes te produceren en raakte twee jaar na de transplantatie zwanger. Haar zoontje kwam eind vorig jaar kerngezond ter wereld.
Lees ook hoe een 3D-geprinte spalk het leven van zieke baby’s heeft gered.
Bronnen: Human Reproduction, Popular Science, IFL Science
Beeld: Erasme Hospital/Université Libre de Bruxelles